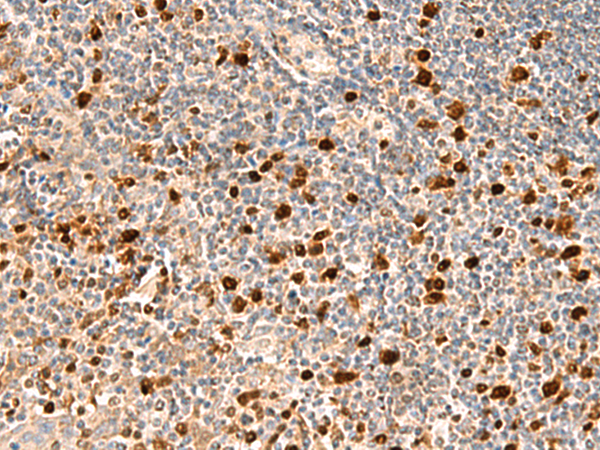
一抗

|
Background: |
This gene encodes an essential enzyme of nucleotide metabolism. The encoded protein forms a ubiquitous, homotetrameric enzyme that hydrolyzes dUTP to dUMP and pyrophosphate. This reaction serves two cellular purposes: providing a precursor (dUMP) for the synthesis of thymine nucleotides needed for DNA replication, and limiting intracellular pools of dUTP. Elevated levels of dUTP lead to increased incorporation of uracil into DNA, which induces extensive excision repair mediated by uracil glycosylase. This repair process, resulting in the removal and reincorporation of dUTP, is self-defeating and leads to DNA fragmentation and cell death. Alternative splicing of this gene leads to different isoforms that localize to either the mitochondrion or nucleus. A related pseudogene is located on chromosome 19. |
|
Applications: |
ELISA, IHC |
|
Name of antibody: |
DUT |
|
Immunogen: |
Fusion protein of human DUT |
|
Full name: |
deoxyuridine triphosphatase |
|
Synonyms: |
dUTPase |
|
SwissProt: |
P33316 |
|
ELISA Recommended dilution: |
5000-10000 |
|
IHC positive control: |
Human tonsil |
|
IHC Recommend dilution: |
50-300 |

 購物車
購物車 幫助
幫助
 021-54845833/15800441009
021-54845833/15800441009